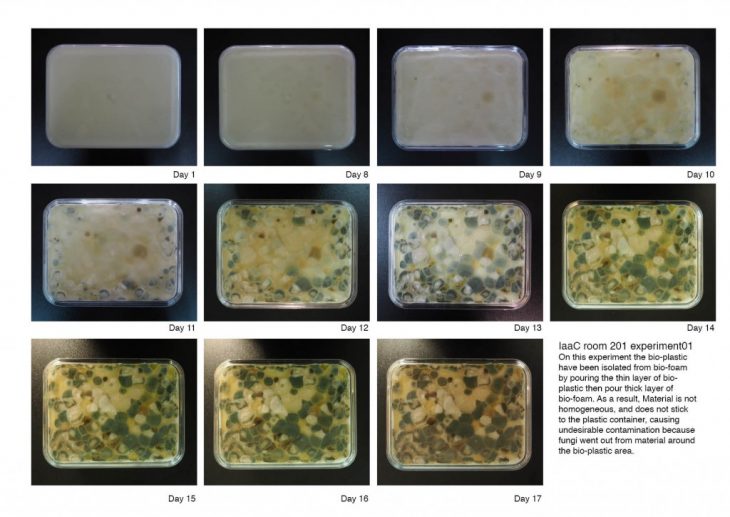

Foaminant-Foam Scaffolds for Mineralised Tissue.
Mixed bio-based foam composites are used as scaffolds for species to proliferate inside and around the materials to harden or soften the designs.
In order to produce the unique designs, the bacteria plays a big role enhancing the material properties either soft and hard. Simultaneously, the material appearance have been changed due to the colonization of species depending on the different environment which could give a variety of bacteria contaminating the container of material then it will grow on the material.
The design of the geometries are based on the feedback loop between digital and physical analysis with the structure analysis software which is capable to analyze the overall geometry comparing with actual chair in physical world, also the local geometry which is computationally designed and inspired by the nature in order to achieve the structural properties both deformation and utilisation of the material, and test with how the actual material behave.
Exploring the fabrication technique with the additive manufacturing process using the kuka robot resulting the precise design which can be reproduced or produce a new design easily.

Foaminant is a project of IaaC, Institute for Advanced Architecture of Catalonia developed at Master in Advanced Architecture, MAA02 in 2016/17 by:
Student:
Inthat Ueasak-aree
Tutor: Marcos Cruz
Assistant: Nina Jotanovic
Biology Support: Nuria Conde Pueyo
Fabrication Support: Alexandre Dubor, Kunaljit Singh Chadha